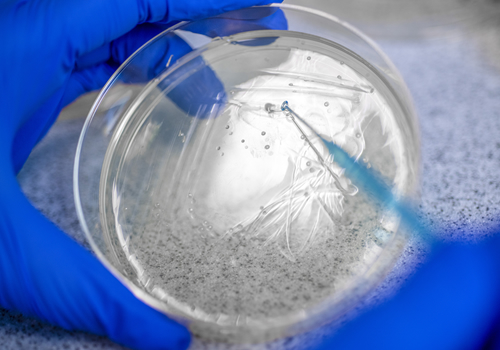
A person is holding a petri dish with a liquid in it.

Center for
Immunotherapy & Precision Immuno-Oncology
The Future of Cancer Treatment
While traditional methods for treating cancer, including chemotherapy and radiation, are often effective at killing cancer cells, they can also kill healthy cells, as well. Cancer researchers around the world are searching for more effective therapies that do not compromise patients' long-term health and wellness. One of the most promising research areas is immunotherapy, which has shown great promise in treating many types of cancer.
Immunotherapies, including immune checkpoint modulators and cell therapy, have revolutionized the treatment of many human diseases. Immunotherapy for cancer has improved the outcomes of many cancers to a level thought impossible even a few years ago and comprise a new family of treatments that are quickly becoming a foundation of modern medicine. Classic immunotherapies such as vaccines are becoming increasingly important in a world threatened by emerging pathogens and antibodies that target discrete molecules have helped patients control various autoimmune ailments. We leverage immunogenomics in personalized cancer treatment for each patient.
The Center for Immunotherapy & Precision Immuno-Oncology (CITI) is a state-of-the-art center dedicated to immunotherapy research, discovery and developmental therapeutics, with the ultimate goal to make precision immuno-oncology available for every patient. Learn more about our mission and goals.
Our Research Divisions & Programs
Our program advances state-of-the-art cell engineering and T cell therapy developmental therapeutics, focusing on clinical development and research. We run cell therapy trials and develop new cell therapy approaches.
.jpg)
Our division advances translational immunology research, specializing in the fields of immuno-oncology, auto-immunity, computational immunology and population immunology.

Our program brings enhanced clinical trials correlates and discovery capabilities to Cleveland Clinic and Case Comprehensive Cancer Center for a wide range of basic and clinical topics.

Our program collaborates with the Cleveland Clinic Cancer Center and Case Comprehensive Cancer Center to provide precision approaches, including immunogenomic profiling, and new immunotherapy trials to patients and investigators.
What is Immunogenomics?
Our program advances state-of-the-art cell engineering and T cell therapy developmental therapeutics, focusing on clinical development and research. We run cell therapy trials and develop new cell therapy approaches.
Learn MoreWhat is Precision Immuno-Oncology?
Precision oncology seeks to understand the unique genetic makeup of each patient's tumor to better tailor more effective treatments. Precision oncology can identify whether standard of care treatment is right for you - or a novel drug available through clinical trials. It is our ultimate goal to leverage immunogenomic profiling to power precision immuno-oncology for all patients receiving immunotherapy treatment, either through clinical trials or commercial treatments.
Learn More
Featured Lab
Jos Melenhorst Lab
The goal of the Melenhorst lab is to develop potent, safe T cell-based gene therapies for hematologic and solid organ malignancies.
Learn More
Featured Lab
Natalie Silver Lab
The Natalie Silver lab is exploring novel ways to reprogram the tumor immune microenvironment to develop therapeutics for head and neck cancers.
Learn More
Featured Lab
Ying Ni Lab
The Ni lab investigates alterations in metabolism-related genes and metabolites could have direct impact in cancer predisposition, tumor progression and immunotherapy treatment response.
Learn MoreResearch News

Second-year Case Western Reserve University PhD student, Mikayla Ybarra, shares how Cleveland Clinic isn't simply where she trains; it's where her identities as scientist, artist and educator come together.

Combining metabolomics and genomics helps identify patients who benefit from immune checkpoint inhibitors for gynecologic cancer.

Two children, a graduate student and a lab full of scientists teamed up to turn complex cancer research into a story worth drawing.
Join Us
Exciting investigation and groundbreaking discovery happens every day at Cleveland Clinic. Join our team of expert researchers at the Center for Immunotherapy & Precision Immuno-Oncology.
View Careers